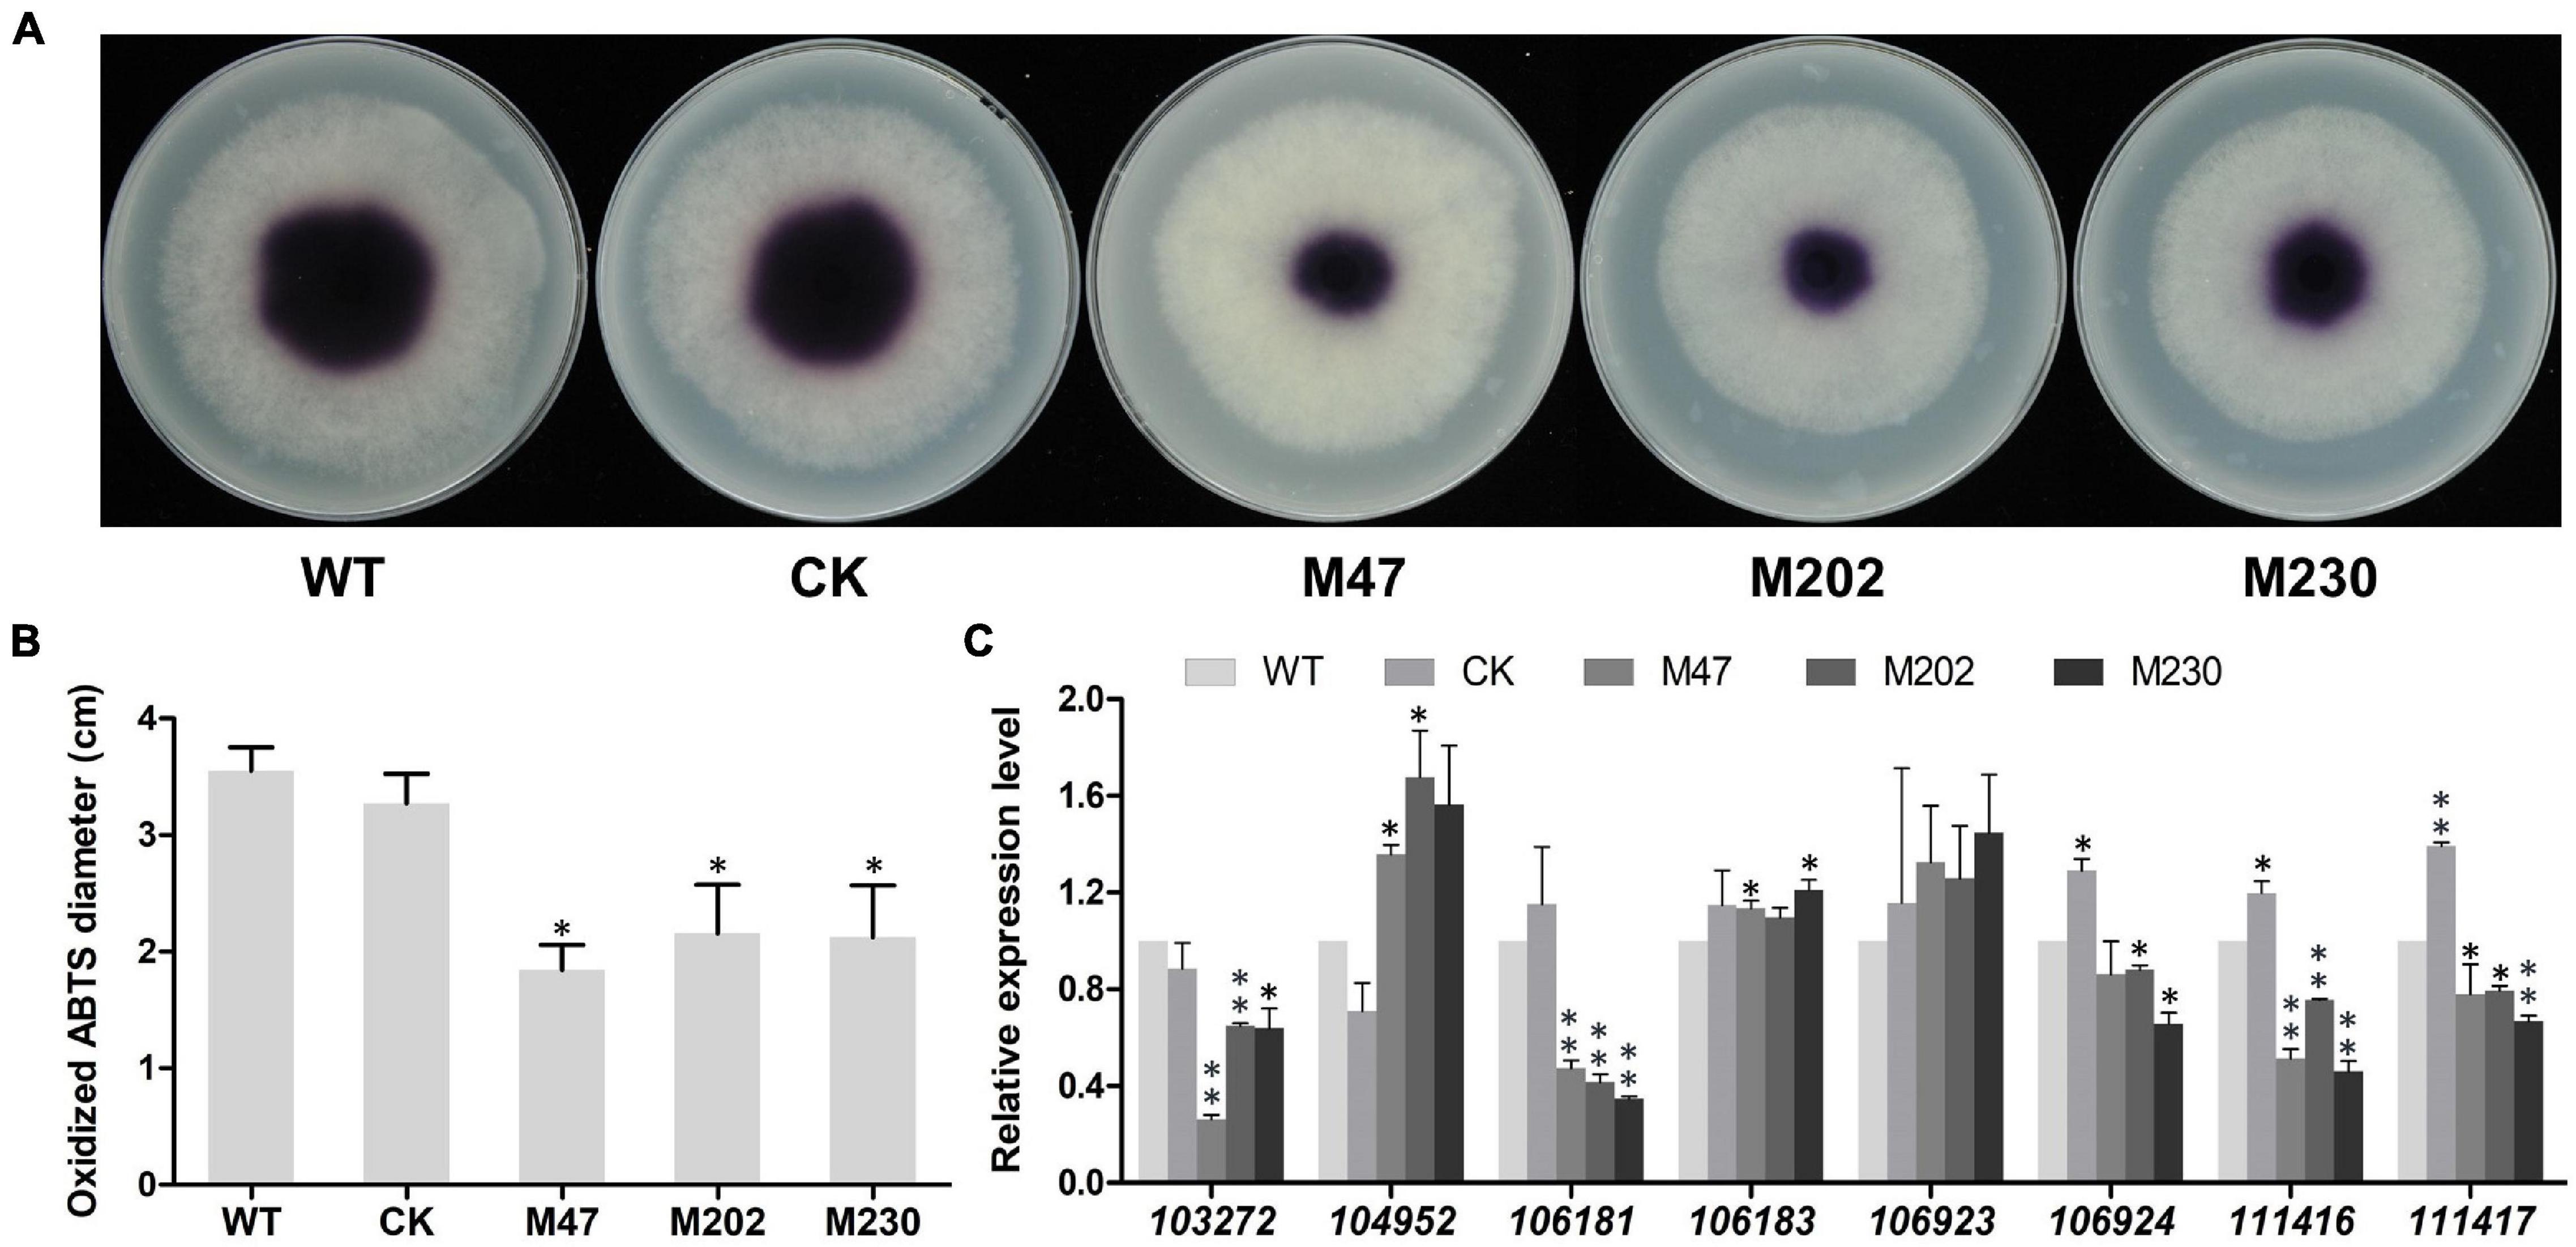

- 1Guangdong Province Key Laboratory of Microbial Signals and Disease Control, Department of Plant Pathology, South China Agricultural University, Guangzhou, China
- 2Integrative Microbiology Research Centre, South China Agricultural University, Guangzhou, China
As an electron transport component, cytochrome b5 is an essential component of the Class II cytochrome P450 monooxygenation system and widely present in animals, plants, and fungi. However, the roles of Cyt-b5 domain proteins in pathogenic oomycetes remain unknown. Peronophythora litchii is an oomycete pathogen that causes litchi downy blight, the most destructive disease of litchi. In this study, we identified a gene, designated PlCB5L1, that encodes a Cyt-b5 domain protein in P. litchii, and characterized its function. PlCB5L1 is highly expressed in the zoospores, cysts, germinated cysts, and during early stages of infection. PlCB5L1 knockout mutants showed reduced growth rate and β-sitosterol utilization. Importantly, we also found that PlCB5L1 is required for the full pathogenicity of P. litchii. Compared with the wild-type strain, the PlCB5L1 mutants exhibited significantly higher tolerance to SDS and sorbitol, but impaired tolerance to cell wall stress, osmotic stress, and oxidative stress. Further, the expression of genes involved in oxidative stress tolerance, including peroxidase, cytochrome P450, and laccase genes, were down-regulated in PlCB5L1 mutants under oxidative stress. This is the first report that a Cyt-b5 domain protein contributes to the development, stress response, and pathogenicity in plant pathogenic oomycetes.
Introduction
Cytochrome b5-like heme/steroid binding domain (Cyt-b5 domain) proteins have been found in all major eukaryotic lineages and a few bacteria (Mifsud and Bateman, 2002). As a physiological electron transport component, cytochrome b5 is an essential component of the Class II cytochrome P450 monooxygenation system (Hlavica, 1984; Zhang and Scott, 1994; Porter, 2002). Cytochrome b5 also interacts with various proteins, including cytochrome b5 reductase, sucrose or sorbitol transporters, cytochrome c (Davydov, 2001; Schenkman and Jansson, 2003; Fan et al., 2009; Gentry et al., 2019) in multiple biological reactions, participating in fatty acid desaturation (Takashi et al., 1972), fatty acid prolongation (Keyes et al., 1979), apoptosis and catabolism of exogenous organisms and drugs (Kandel and Lampe, 2014). Some cytochrome b5 fuse with additional domains, such as fatty acid desaturase, sulfite oxidase, nitrate reductase, or chitin synthase (Sayanova et al., 1997; Rudolph et al., 2003; Ikeyama et al., 2010; Kong et al., 2012).
In Arabidopsis thaliana, a Cyt-b5 domain protein, RLF, is involved in lateral root initiation, while RLF and its homologs are highly conserved among a variety of plant species (Ikeyama et al., 2010). In vertebrates, progesterone receptor membrane component 1 (PGRMC1) is a membrane-bound progesterone receptor containing a Cyt-b5 domain, relating to steroid synthesis and metabolism (Mifsud and Bateman, 2002; Kimura et al., 2012). Furthermore, Cytochrome P450s and the cytochrome b5 reductase-cytochrome b5 system have been reported to play an important role in the synthesis of sterols in fungi, which are indispensable for fungal hyphal growth and asexual sporulation (Lamb et al., 1999; Derbyshire et al., 2015). In Saccharomyces cerevisiae, heterologous expression of Aspergillus oryzae D9D genes, AoD9D1 and AoD9D2, which encode proteins containing fatty acid desaturase and Cyt-b5 domain, contribute to the accumulation of unsaturated fatty acid and tolerance of high salinity stress depending on both the fatty acid desaturase and Cyt-b5 domain (Li et al., 2019). However, our knowledge of the function of Cyt-b5 domain proteins in plant pathogenic oomycetes is still lacking.
Oomycetes include many notorious plant and animal pathogens, resulting in significant global losses in agriculture, forestry, and aquaculture (Thines, 2018). Litchi downy blight caused by the oomycete pathogen, Peronophythora litchii, is a major disease of litchi and leads to huge production losses (Jiang et al., 2017; Liu et al., 2017; Kong et al., 2020). The P. litchii infects fruits, flowers, leaves, and twigs, causing panicle rot, fruit brown, and leaf blight (Kong et al., 2021). The recent publication of P. litchii genome has greatly accelerated the molecular research of this pathogen (Ye et al., 2016). P. litchii PlAvh142, PlPAE5, PlBZP32, PlM90, PlMAPK2, and PlMAPK10 were found to be associated with the development and/or virulence of P. litchii (Jiang et al., 2018; Kong et al., 2019, 2020; Situ et al., 2020a; Huang et al., 2021). However, the molecular mechanisms of development and pathogenicity of P. litchii are still largely unknown.
A better understanding of the development and virulence of P. litchii is crucial for the control of litchi downy blight. In this study, we identified a Cyt-b5 domain protein, PlCB5L1, in P. litchii and carried out functional characterization of PlCB5L1. We found that PlCB5L1 is conserved in oomycetes and up-regulated in zoospores, cysts, germinated cysts, and early stages of infection. We knocked out this gene by CRISPR/Cas9 technique and found that PlCB5L1 contributed to mycelial growth and utilization of β-sitosterol. Meanwhile, deletion of PlCB5L1 impaired the H2O2 tolerance, laccase activity and pathogenicity of P. litchii. Further study showed that expression of peroxidase, cytochrome P450, and laccase genes were down-regulated in PlCB5L1 knockout mutants. The study demonstrated the role of PlCB5L1 in growth, H2O2 tolerance, and pathogenicity.
Materials and Methods
Identification and Phylogenetic Analysis of Cyt-b5 Domain Proteins
The genome sequence and gene annotations of P. litchii were obtained from NCBI (BioProject ID: PRJNA290406). Translated protein sequences of all P. litchii genes were analyzed using InterProScan5 (version 5.46) to identify proteins with the cytochrome b5-like heme/steroid binding domain. The amino acid sequence alignment was generated and adjusted in BioEdit (version 7.0.9.1).
Peronophythora litchii Strain and Culture Conditions
P. litchii wild type (WT) strain SHS3 (Ye et al., 2016), the CK strain, and Δplcb5l1 mutants were cultured on carrot juice agar (CJA) medium (juice from 300 g carrot for 1 L medium, 15 g agar/L for solid media) at 25°C in darkness. The control (CK) strain is a transformant that failed to knockout PlCB5L1. Litchi leaves were harvested from healthy litchi trees in an orchard in South China Agricultural University, Guangzhou, Guangdong province, China. For sporangia production, five 9 mm diameter mycelial plugs were flushed with 2 mL sterilized water, filtering the subsequent suspension with a 100 μm mesh filter. The suspension was incubated at 16°C for 1 h, for zoospores release. After shaking the suspension for 30 s on a vortex oscillator, zoospores were encysted. Cysts were incubated at 25°C 60 rpm for 0.5 h, for cysts germinating. The number of sporangia, release rate of zoospores, and germination rate of cysts were counted under a microscope. The number of oospores was calculated from three 9 mm diameter zones, at 10th days after inoculating on CJA medium at 25°C in the dark (Jiang et al., 2017).
Nucleic Acid Extraction and Quantitative Reverse Transcription PCR
Fungal genomic DNA was extracted from mycelia grown in CJA medium or infected litchi leaves using a Fungal DNA Kit (Omega, America). PCR amplification was performed using Phanta Max Super-Fidelity DNA Polymerase (Vazyme, China). PCR product purification was performed using Cycle Pure Kit (Omega, America) or Gel Extraction Kit (Omega, America). Total RNAs from the life cycle stages of P. litchii, including mycelia, sporangia, zoospores, cysts, germinated cysts, oospores, and stages of infection, were extracted using All-In-One DNA/RNA Mini-preps Kit (Bio Basic, China). FastKing RT Kit (TIANGEN, China) was used for the first-strand cDNA synthesis. The cDNA was stored at –20°C. The expression profile of PlCB5L1 was analyzed with qRT-PCR using SYBR® Premix Ex Taq™ II (TaKaRa, Japan) and primers PlCB5L1-qRTF/R. P. litchii actin gene (PlActin) (Jiang et al., 2017) was used as a loading control and the relative fold change was calculated using the 2–ΔΔCT method (Livak and Schmittgen, 2001). Primers used for these analyses were listed in Supplementary Table 1.
CRISPR/Cas9 Editing for PlCB5L1 Knockout
A SgRNA was selected and inserted into the sgRNA vector pYF2.3G-RibosgRNA as previously described (Fang and Tyler, 2016; Situ et al., 2020b). To generate gene replacement constructs, 1 kb long upstream/downstream arms of the PlCB5L1 coding region were inserted into pBluescript II KS vector using the ClonExpress MultiS One Step Cloning Kit (Vazyme, China) (Figure 1A). The pYF2.3G-RibosgRNA (PlCB5L1) vector, the hSPCas9 vector pYF2-PsNLS-hSpCas9, and the pBluescript II KS (PlCB5L1) vector were co-transformed into protoplasts of strain SHS3 using PEG-mediated protoplast transformation (Fang and Tyler, 2016). Preliminary transformants were screened by CJA medium containing 50 μg/mL G418. These transformants were further verified by genomic PCR and sequencing. These primers were listed in Supplementary Table 1.

Figure 1. Gene knockout of PlCB5L1. (A) CRISPR/Cas9-mediated knockout of PlCB5L1, in which the NPTII gene replaces the PlCB5L1. The primers (F1, R1, and F2, R2) used for PCR analysis are indicated by horizontal arrows. F1: Left-out-F; F2: NPTII-F; R1: NPTII-R; R2: Left-out-R (Supplementary Table 1). (B) Genomic DNA PCR analysis of the Δplcb5l1 mutants. Marker: DL 5000. Lane 1, lane 4, lane 7, and lane 10 were amplifying with primers F1/R2. Lane 2, lane 5, lane 8, and lane 11 were amplifying with primers F1/R1. Lane 3, lane 6, lane 9, and lane 12 were amplifying with primers F2/R2. (C) Sequence analysis of the Δplcb5l1 mutants. (D) Relative gene expression levels of PlCB5L1 in mutants and CK strains. The expression level of WT was set as 1. Data are mean ± SD (n = 9). Asterisks represent significant difference (***p < 0.001) based on statistics analysis using Student’s t-test.
Pathogenicity Assays on Litchi Leaves
Pathogenicity assays were performed by inoculating 10 μL (20 zoospores per μL) of zoospore suspensions of P. litchii WT, CK, and Δplcb5l1 mutants (M47, M202 and M230) on the abaxial side of litchi leaves at 25°C in the dark. Lesion diameters were measured and photographed 48 h after inoculation. The relative biomass was determined by the ratio of P. litchii DNA to litchi DNA in the inoculated tissues by qRT-PCR using the specific primers for P. litchii and litchi Actin genes (Supplementary Table 1; Zhong et al., 2011). The significant differences were analyzed with Student’s t-test and three independent replicates were set up, with at least 6 leaves in each replicate.
Sensitivity to Various Stress
To investigate the sensitivity of PlCB5L1 mutants under different stress conditions, the mycelial plugs (diameter = 9 mm) of Δplcb5l1 mutants were inoculated in the center of the Plich medium (van West et al., 1999) and cultured at 25°C in the dark for 7 days. The Plich media were supplemented with different concentrations of sodium dodecyl sulfate (SDS), Congo Red (CR), Calcofluor White (CFW), H2O2, sorbitol, NaCl or CaCl2. WT and CK strains were used as control. The growth inhibition rate was calculated as: growth inhibition rate (%) = (growth diameter on stress-free plates—growth diameter on stress plates)/growth diameter on stress-free plates × 100%.
To analyze the expression of PlCB5L1 under oxidative stress, the WT strain was cultured in liquid Plich medium for 3 days at 25°C in the dark. The mycelia were immersed in the liquid medium supplemented with 5 mM H2O2 for 0, 5, 15 or 55 min. All samples were harvested and the expressional levels of PlCB5L1 were evaluated by qRT-PCR.
Diaminobenzidine Staining
DAB staining was performed to visualize the accumulation of reactive oxygen species (ROS) in the infected leaves. The infected leaves were stained with 1 mg/mL DAB solution at room temperature in the dark for 8 h, and then decolorized in 96% ethanol for 48 h (Molina and Kahmann, 2007). ImageJ was used to record the grayscale values of all pixels within the brown areas in the infected leaves.
Results
Phylogenetic Analysis and the Transcriptional Profiles of PlCB5L1
We screened all proteins encoded in the genome of P. litchii (Ye et al., 2016) using InterProScan and identified 11 Cyt-b5 superfamily members. In addition to the cytochrome b5-like heme/steroid binding domain (Cyt-b5), some proteins also contain additional domains, including the flavin adenine dinucleotide domain (FAD), fatty acid desaturases domain (FA_desaturase), molybdopterin cofactor oxidoreductase dimerization domain (Mo-co_dimer), cGMP-specific phosphodiesterases, adenylyl cyclases, and FhlA (GAF) domain, and oxidoreductase molybdopterin binding domain (Oxidored_molyb) domain (Supplementary Figure 1). Among them, Pl109805 (named PlCB5L1) showed the highest transcriptional levels during infection among the 11 Cyt-b5 superfamily members, and is dramatically up-regulated in the stages of infection (based on unpublished transcriptome data). Furthermore, the expression profile of the PlCB5L1 were determined by quantitative reverse-transcription polymerase chain reaction (qRT-PCR). Compared with mycelial stage, PlCB5L1 had much higher expression levels in zoospores, cysts, cyst germination, and the early stages of plant infection (1.5 and 3 h post-inoculation, hpi) (Figure 2), suggesting that PlCB5L1 may have important roles in the colonization and early infection of P. litchii. Therefore, we characterized the function of PlCB5L1 in this study.

Figure 2. Expression pattern of PlCB5L1 during the sexual, asexual and infection stages of P. litchii. Expression levels were determined by qRT-PCR using RNAs extracted from vegetative mycelia (MY), sporangia (SP), zoospores (ZO), cysts (CY), germinated cysts (GC), oospores (Oo), and samples from 1.5, 3, 6, 12, and 24 h post-inoculation with zoospores on leaves. The relative expression levels were calculated by using the MY sample as reference. Data are mean ± SD (n = 9). The data were statistically analyzed with SPSS (version 20.0) with Duncan’s Multiple Range Test method and different letters denote statistical differences (p < 0.05).
PlCB5L1 encodes a protein of 160 amino acids (aa) and its Cyt-b5 domain is located in the C-terminal of the protein (64–160 aa). Sequence analyses showed that a single ortholog of PlCB5L1 is present in each of the 19 sequenced oomycetes and the levels of protein sequence similarity between PlCBL5L1 and its orthologs range between 51.70 and 96.30%, indicating that PlCB5L1 is well-conserved in oomycetes (Supplementary Table 2 and Figure 3). We also compared PlCB5L1 with its most similar homologs in other eukaryotes including fungi, animals, and plants, they possess high levels of sequence divergence (protein sequence similarity < 45%) (Supplementary Table 2).

Figure 3. Domain arrangement of PlCB5L1 protein and its orthologs. Protein sequence alignment of PlCB5L1 and its orthologs from 19 oomycete species. Columns with identical and similar amino acid sequences were colored black and gray, respectively. The red box indicates Cyt-b5 domain.
Generation of PlCB5L1 Knockout Mutants by CRISPR/Cas9 Genome Editing Method
We generated three PlCB5L1 knockout mutants (M47, M202, and M230) using the CRISPR/Cas9 system, as previously described (Fang and Tyler, 2016; Situ et al., 2020b; Figure 1A). Genomic PCR assays and sequencing results proved that PlCB5L1 was replaced with the NPTII gene in the three mutants (Figures 1B,C). Subsequently, qRT-PCR analysis confirmed that PlCB5L1 was not expressed in these mutants (Figure 1D). A transformant that failed to knockout PlCB5L1 was selected as the control (CK) strain.
PlCB5L1 Is Required for the Growth and Utilization of β-Sitosterol
To investigate the biological functions of PlCB5L1, the sexual and asexual phenotypes of the Δplcb5l1 mutants, CK and wild-type strains (WT) were examined. We cultured the Δplcb5l1 mutants, WT and CK strains on CJA medium for 5 days at 25°C in the dark, and measured the colony diameter of each strain. As shown in Figures 4A,B, the average growth rates (mm/day) of the mutants (10.45–11.20) were significantly lower than that of the WT (12.19) and CK (12.05), suggesting that PlCB5L1 contributes to the vegetative growth of P. litchii.

Figure 4. Growth rate and β-sitosterol utilization of WT, CK, and the Δplcb5l1 mutants. (A) Colonies of three independent Δplcb5l1 mutants (M47, M202, and M230), WT and CK strains were cultured on CJA medium at 25°C in the dark for 5 days. (B) Growth-rates were measured on CJA medium. (C) Promotion ratio (%) of WT, CK, and Δplcb5l1 mutants under the condition of Plich medium adding 10 mg/L or 20 mg/L β-sitosterol. The values are mean ± SD (n = 9). The data were statistically analyzed with Duncan’s Multiple Range Test method, with significant differences defined as **p < 0.01.
Previous studies have shown that Phytophthora spp. cannot synthesize sterols on their own; instead, they use sterol carrier protein elicitins to absorb and metabolize many kinds of sterols from host plants (Boissy et al., 1999; Dahlin et al., 2017). β-sitosterol is one of the most abundant sterols within plant tissues and is useful for mycelial growth of P. infestans in V8 agar medium (Medina and Platt, 1999; Klingberg et al., 2008; Stong et al., 2013). We examined the function of PlCB5L1 on β-sitosterol utilization by culturing Δplcb5l1 mutants, WT, and CK on Plich medium supplemented with 10 mg/L or 20 mg/L β-sitosterol. Their colony diameters were measured 5 days after inoculation at 25°C in the dark. Results showed that the growth-promoting rates of WT and CK were significantly (p < 0.05) higher than that of mutants on Plich medium with 10 or 20 mg/L β-sitosterol (Figure 4C), suggesting that the Δplcb5l1 mutants have impaired capability of β-sitosterol utilization compared with WT and CK.
Next, we evaluated the sporangia number, sporangia size, the rate of zoospores release and cysts germination, as well as the number of produced oospores. Our results showed that the knockout of PlCB5L1 did not have a significant impact on these phenotypes (Supplementary Figure 2).
PlCB5L1 Is Required for the Full Virulence of P. litchii
To determine the role of PlCB5L1 in the pathogenicity of P. litchii, the abaxial surface of tender litchi leaves were inoculated with zoospores suspensions (20 per μL) of WT, CK, and Δplcb5l1 mutants (M47, M202, and M230), and kept at 25°C. At 2 days post-inoculation (dpi), we measured the lesion diameter (Figure 5A) and found that the lesions caused by Δplcb5l1 mutants were significantly (p < 0.05) smaller than WT and CK strains (Figure 5B). Biomass quantification confirmed that the amounts of Δplcb5l1 mutants DNA in litchi leaves were at least 40% lower than that of WT and CK (Figure 5C). These results suggest that PlCB5L1 is required for the full virulence of P. litchii.

Figure 5. Pathogenicity test of P. litchii Δplcb5l1 mutants, WT and CK. (A) Litchi leaves were inoculated with 200 zoospores of WT, CK, three Δplcb5l1 mutants M47, M202, and M230 for 48 h at 25°C in the dark. Images showed representative leaves for each instance. (B) Lesion lengths were measured 2 dpi. Data are mean ± SD (n = 9) (*p < 0.05; Duncan’s multiple range test). (C) Relative P. litchii biomass was measured to evaluate the severity of infection by qRT-PCR. Data are mean ± SD (n = 9). Asterisks represent significant difference (**p < 0.01; t-test range test).
PlCB5L1 Is Involved in Cell Wall Integrity and Tolerance to H2O2, Osmotic and Salt Stress
To investigate whether PlCB5L1 is related to various abiotic stress responses of P. litchii, the Δplcb5l1 mutants, WT and CK strains were cultured on Plich medium supplemented with different concentrations of sodium dodecyl sulfate (SDS), Congo red (CR), calcofluor white (CFW), H2O2, sorbitol, NaCl or CaCl2. Colony diameter was measured after 7 days of growth at 25°C in the dark (Figure 6A).

Figure 6. PlCB5L1 is involved in stress tolerance. (A) Assay of mycelial growth of WT, CK, and Δplcb5l1 mutants on Plich medium only or supplemented with 25 μg/mL SDS, 350 μg/mL CR, 100 μg/mL CFW, 2.0 mM H2O2, 0.05 M NaCl, 0.1 M CaCl2, and 0.2 M Sorbitol. Images were taken 7 days post inoculation. (B) Colony diameters were measured 7 days after inoculation. Rates of growth inhibition were calculated for each treatment relative to growth rate on Plich medium. Data are mean ± SD (n = 9). and asterisks denote significant differences between Δplcb5l1 mutants and the WT (**p < 0.01; Duncan’s multiple range test).
The growth inhibition rates of Δplcb5l1 mutants were significantly (p < 0.01) lower than that of WT and CK under the cell wall stress caused by 25 μg/mL SDS and the osmotic stresses caused by 0.2 M sorbitol (Figures 6A,B). On the other hand, Δplcb5l1 mutants were more sensitive to the cell wall stress caused by 350 μg/mL CR and 100 μg/mL CFW, the oxidative stress caused by 2.0 mM H2O2, and the salt stress caused by 0.05 M NaCl and 0.1 M CaCl2 (Figures 6A,B). These results suggest that the function of PlCB5L1 is related to osmoregulation, cell wall integrity, and tolerance to salt and H2O2.
PlCB5L1 Is Required for Detoxifying the Plant Oxidative Burst
Our abovementioned results showed that Δplcb5l1 mutants were more sensitive to H2O2 than WT and CK (Figures 6A,B). To investigate the expression levels of PlCB5L1 under oxidative stress, the hyphae of WT were exposed to 5 mM H2O2-added Plich medium for 0, 5, 15, and 55 min, in order to simulate oxidative stress imposed by the host upon infection. The qRT-PCR analysis showed that PlCB5L1 expression is significantly up-regulated (p < 0.05) at 15 and 55 min after H2O2 treatment (Figure 7A).

Figure 7. PlCB5L1 is associated with the accumulation of ROS and the expression of peroxidase- and cytochrome P450-encoding genes. (A) Transcriptional analysis of the PlCB5L1 gene during oxidative stress (5 mM H2O2, for 0, 5, 15, 55 min). Expression levels were normalized using the values at 0 min as “1.” Asterisks represent significant difference, and Data are mean ± SD (n = 9). (B) ROS accumulation of litchi leaves was detected by DAB staining at 18 h after inoculation. (C) The DAB staining was quantified by ImageJ, which was used to record the grayscale values of all pixels within the brown areas. Data are mean ± SD (n = 9). (D,E) qRT-PCR analysis of P. litchii putative peroxidase-encoding genes and cytochrome P450-encoding genes in Δplcb5l1 mutants, CK and WT strain under oxidative stress conditions (5 mM H2O2, for 5 min). Data are mean ± SD (n = 9). Asterisks represent significant differences (*p < 0.05 or **p < 0.01) based on Student’s t-test.
Since ROS are known to play a key role in many plant-pathogen interactions (Lamb and Dixon, 1997), ROS accumulation was detected by DAB staining. There is a higher level of H2O2 accumulation in litchi leaves inoculated with Δplcb5l1 mutants compared with WT and CK strains at 18 h post-inoculation (Figures 7B,C), suggesting that the Δplcb5l1 mutants showed lower capability of scavenging ROS.
Knockout of PlCB5L1 Attenuates the Expression Levels of Extracellular Peroxidases and Cytochrome P450 Genes
To further investigate the role of PlCB5L1 in scavenging host-derived ROS, we examined the expression levels of five peroxidases and six cytochrome P450 (CYP) genes in WT strain and the Δplcb5l1 mutants. These genes possess highly expression levels in WT strain, based on RNA-seq data (Unpublished). After soaking mycelia in 5 mM H2O2-added Plich medium for 5 min, the expression levels of three peroxidase genes (Pl101341, Pl110273, Pl100432) (Figure 7D) and five CYP genes (Pl113076, Pl110055, Pl103820, Pl103856, Pl112304) were significantly (32∼83 and 36∼86%, respectively) lower in Δplcb5l1 mutants comparing with WT (Figure 7E). These results suggest that PlCB5L1 can affect the expression of these peroxidase genes and CYP genes under oxidative stress.
Knockout of PlCB5L1 Can Weaken the Activity of Extracellular Laccase and Decrease the Expression of Laccase-Encoding Gene
Extracellular laccase activity has been shown to be an important component of plant pathogens defense against oxidative stress (Mayer and Staples, 2002; Yang et al., 2012), therefore we analyzed the laccase activity in Δplcb5l1 mutants, WT and CK strains following an established protocol (Sheng et al., 2015). In the 0.2 mM 2,2-azobis (3-ethylbenzothiazoline-6-sulfonic acid) (ABTS)-added lima bean agar (LBA) medium, the three mutants accumulated significantly (p < 0.05) lower amounts of oxidized ABTS than WT and CK strains, at 7 days after inoculation, suggesting that Δplcb5l1 mutants had lower laccase activity (Figures 8A,B).
Figure 8. Knockout of PlCB5L1 decreased the activity of extracellular laccase and transcription levels of laccase-encoding genes. (A) Laccase activity was determined by monitoring oxidized ABTS (purple color) in LBA media supplemented with 0.2 mM ABTS, photographs were taken 7 days after inoculation. (B) The diameters of oxidized ABTS (dark purple) were measured at 7 days post inoculation. (C) Relative expression of eight laccase-encoding genes in WT (set at 1), CK and Δplcb5l1 mutants under oxidative stress conditions, 5 mM H2O2 for 5 min. Data are mean ± SD (n = 9, **p < 0.01, *p < 0.05; Student’s t-test).
We then examined whether this reduction in laccase activity was due to the down-regulation of laccase genes. We focused on eight laccase genes (Pl103272, Pl104952, Pl106181, Pl106183, Pl106923, Pl106924, Pl111416, and Pl111417), which were selected because they are highly expressed in WT during oxidative stress (5 mM H2O2) and their proteins possess signal peptides (Huang et al., 2021). In Δplcb5l1 mutants, the expression levels of four (Pl103272, Pl106181, Pl111416, and Pl111417) laccase-encoding genes were significantly decreased (Figure 8C).
Discussion
Cytochrome b5-like heme/steroid binding domain proteins are widely present in eukaryotes. The interactions between Cyt-b5 domain proteins and various proteins, such as progesterone receptor membrane component 1 and 2, chitin synthases, fatty acid desaturases, have important roles in multiple biological processes (Napier et al., 1999; Mifsud and Bateman, 2002; Kimura et al., 2012; Kong et al., 2012). In this study, we identified a member of the P. litchii cytochrome b5 superfamily, PlCB5L1, that is well conserved in all sequenced oomycetes. Knockout of PlCB5L1 resulted in reduced mycelial growth rate and utilization of β-sitosterol, significantly attenuated P. litchii virulence on litchi plants, as well as substantially altered expression of peroxidase, cytochrome P450, and laccase genes. This is the first report that a Cyt-b5 domain protein contributes to growth, β-sitosterol utilization, virulence, and oxidative response in plant pathogenic oomycetes.
Some Cyt-b5 domain proteins (e.g., PGRMC1 and ZtCytb5) are involved in sterol biosynthesis and ZtCytb5 is necessary to the mycelial growth in Zymoseptoria tritici (Kimura et al., 2012; Derbyshire et al., 2015). Here, we found that the mycelial growth rates of the Δplcb5l1 mutants were significantly lower than that of WT (Figures 4A,B), and the mutants also showed impaired utilization of β-sitosterol (Figure 4C). We infer that the reduction in growth rate may be caused by the decrease of lipid rafts, which are highly enriched in sterols and sphingolipids (Martin and Konopka, 2004). Cytochrome b5 reductase—cytochrome b5 system plays a major role in the electron transfer of desaturase and hydroxylase; it can catalyze the biosynthesis of sphingomyelin, sterols, and various unsaturated fatty acid (Michaelson et al., 2013). However, PlCB5L1 protein has a unique Cyt-b5 structure and does not contain a distinct domain with potential enzymatic activity, suggesting that PlCB5L1 may not participate in the biosynthesis of sterols. Phytophthora spp. cannot synthesize sterols on its own, but can instead absorb and metabolize many kinds of sterols from host plants by sterol carrier protein elicitins, which are associated with mycelial growth (Nes and Stafford, 1983; Boissy et al., 1999; Gaulin et al., 2010; Dahlin et al., 2017). Therefore, we inferred that PlCBL1 might be a component for the utilization of sterols.
Under high concentrations of salt, which disrupt cell homeostasis and cause osmotic stress, microorganisms would increase the levels of unsaturated fatty acids to preserve normal membrane fluidity (Srivastava et al., 2014). Cytochrome b5 proteins have been found to be involved in fatty acid desaturation (Takashi et al., 1972). For instance, Li et al. (2019) transformed Cyt-b5 domain of the delta-9 fatty acid desaturase from A. oryzae into S. cerevisiae and the transformed strains showed enhanced accumulation of unsaturated fatty acid and stronger salt tolerance than the wild type. Similarly, our results here showed that Δplcb5l1 mutants were more sensitive to the salt stress caused by NaCl and CaCl2 (Figure 6), which might be caused by the disruption of fatty acid desaturation in the Δplcb5l1 mutants.
In host plants, one characteristic early defense response is the rapid production and accumulation of peroxides after the perception of non-toxic signals of pathogens (Lamb and Dixon, 1997). On the other hand, pathogens have also evolved mechanisms to scavenge host ROS by producing peroxidases, cytochrome P450s, and laccases (Molina and Kahmann, 2007; Chi et al., 2009; Matteis et al., 2012; Yang et al., 2012). In our study, we found that the expression level of PlCB5L1 was significantly up-regulated after 15 min of H2O2 treatment (Figure 7A), suggesting that PlCB5L1 might be involved in the oxidative stress response of P. litchii. Additionally, the expression levels of three peroxidase genes and five cytochrome P450 genes were significantly lower in the PlCB5L1 knockout mutants than that of WT strain, under oxidative stress conditions (Figures 7D,E). The function of cytochrome b5-cytochrome b5 reductase electron transfer system in cytochrome P450 monooxygenation has long been recognized in animals and fungi (Syed et al., 2011). There is also a report that Cytb5 electron transfer plays a role in peroxidase activity (Bidlack, 1980). We infer that PlCB5L1 is related to the expression of these peroxidase genes and cytochrome P450 genes during oxidative stress.
We also found that one CYP-encoding gene (Pl112304) which showed significantly decreased expression in Δplcb5l1 mutants is a homolog of pisatin demethylase (GenBank ID: AAR32716.1). Pisatin demethylase (PDA), the enzyme responsible for detoxifying pisatin, is a substrate-inducible CYP-encoding gene (George et al., 1998; Coleman et al., 2011). It is therefore possible that the decrease of virulence of Δplcb5l1 mutants is related to the decrease of degradation ability of antimicrobial compounds. However, the detailed mechanism needs to be further verified.
Overall, our study represents the first report that cytochrome b5 superfamily member PlCB5L1 is associated with growth and β-sitosterol utilization. PlCB5L1 also plays a key role in pathogenesis and response to oxidative stress, likely via the affecting activity of laccase and the expression of genes encoding peroxidases, cytochrome P450s, and laccases. The functional characterization of PlCB5L1 provides new insights into the mycelial growth, stress resistance, pathogenesis, and laccase activity of P. litchii. Future studies are needed to elucidate the roles of PlCB5L1 in the growth, development, and pathogenicity of P. litchii via functionally interacting with P450, laccase, and peroxidase.
Data Availability Statement
The original contributions presented in the study are included in the article/Supplementary Material, further inquiries can be directed to the corresponding author/s.
Author Contributions
ZJ, GK, WL, and XZ designed experiments. WL, PL, XZ, JS, YL, YY, and JQ performed the experiments. WL and GK analyzed the data. GK, ZJ, and WL discussed and developed the study. WL, XZ, GK, and ZJ wrote the manuscript. All authors contributed to the article and approved the submitted version.
Funding
This work was supported by the earmarked grant for China Agriculture Research System (CARS-32-11), the Natural Science Foundation of Guangdong Province, China (2020A1515011335), and the National Natural Science Foundation of China (31701771).
Conflict of Interest
The authors declare that the research was conducted in the absence of any commercial or financial relationships that could be construed as a potential conflict of interest.
Publisher’s Note
All claims expressed in this article are solely those of the authors and do not necessarily represent those of their affiliated organizations, or those of the publisher, the editors and the reviewers. Any product that may be evaluated in this article, or claim that may be made by its manufacturer, is not guaranteed or endorsed by the publisher.
Acknowledgments
We thank Brett Tyler (Oregon State University, United States) and Wenwu Ye (Nanjing Agricultural University, China) for the plasmids and sequence analyses. We are grateful for the critical reading our manuscript by Yi Zhen Deng (South China Agricultural University) and Suomeng Dong (Nanjing Agricultural University).
Supplementary Material
The Supplementary Material for this article can be found online at: https://www.frontiersin.org/articles/10.3389/fpls.2021.783438/full#supplementary-material
References
Bidlack, W. R. (1980). Microsomal peroxidase activities-effect of cumene hydroperoxide on the pyridine nucleotide reduced cytochrome b5 steady state. Biochem. Pharmacol. 29, 1605–1608. doi: 10.1016/0006-2952(80)90619-X
Boissy, G., O’Donohue, M., Gaudemer, O., Perez, V., Pernollet, J. C., and Brunie, S. (1999). The 2.1 A structure of an elicitin-ergosterol complex: a recent addition to the Sterol Carrier Protein family. Protein Sci. 8, 1191–1199. doi: 10.1110/ps.8.6.1191
Chi, M. H., Park, S. Y., Kim, S., and Lee, Y. H. (2009). A novel pathogenicity gene is required in the rice blast fungus to suppress the basal defenses of the host. PLoS Pathog. 5:e1000401. doi: 10.1371/journal.ppat.1000401
Coleman, J. J., Wasmann, C. C., Usami, T., White, G. J., Temporini, E. D., McCluskey, K., et al. (2011). Characterization of the gene encoding pisatin demethylase (FoPDA1) in Fusarium oxysporum. Mol. Plant Microbe Interact. 24, 1482–1491. doi: 10.1094/MPMI-05-11-0119
Dahlin, P., Srivastava, V., Ekengren, S., Mckee, L. S., and Bulone, V. (2017). Comparative analysis of sterol acquisition in the oomycetes Saprolegnia parasitica and Phytophthora infestans. PLoS One 12:e170873. doi: 10.1371/journal.pone.0170873
Davydov, D. R. (2001). Microsomal monooxygenase in apoptosis: another target for cytochrome c signaling? Trends Biochem. Sci. 26, 155–160. doi: 10.1016/s0968-0004(00)01749-7
Derbyshire, M. C., Michaelson, L., Parker, J., Kelly, S., Thacker, U., Powers, S. J., et al. (2015). Analysis of cytochrome b5 reductase-mediateds metabolism in the phytopathogenic fungus Zymoseptoria tritici reveals novel functionalities implicated in virulence. Fungal Genet. Biol. 82, 69–84. doi: 10.1016/j.fgb.2015.05.008
Fan, R. C., Peng, C. C., Xu, Y. H., Wang, X. F., Li, Y., Shang, Y., et al. (2009). Apple sucrose transporter SUT1 and sorbitol transporter SOT6 interact with cytochrome b5 to regulate their affinity for substrate sugars. Plant Physiol. 150, 1880–1901. doi: 10.1104/pp.109.141374
Fang, Y., and Tyler, B. M. (2016). Efficient disruption and replacement of an effector gene in the oomycete Phytophthora sojae using CRISPR/Cas9. Mol. Plant Pathol. 17, 127–139. doi: 10.1111/mpp.12318
Gaulin, E., Bottin, A., and Dumas, B. (2010). Sterol biosynthesis in oomycete pathogens. Plant Signal Behav. 5, 258–260. doi: 10.4161/psb.5.3.10551
Gentry, K. A., Anantharamaiah, G. M., and Ramamoorthy, A. (2019). Probing protein-protein and protein-substrate interactions in the dynamic membrane-associated ternary complex of cytochromes P450, b5 and reductase. Chem. Commun. 55, 13422–13425. doi: 10.1039/c9cc05904k
George, H. L., Hirschi, K. D., and Vanetten, H. D. (1998). Biochemical properties of the products of cytochrome P450 genes (PDA) encoding pisatin demethylase activity in Nectria haematococca. Arch. Microbiol. 170, 147–154. doi: 10.1007/s002030050627
Hlavica, P. (1984). On the function of cytochrome b5 in the cytochrome P450-dependent oxygenase system. Arch. Biochem. Biophys. 228, 600–608. doi: 10.1016/0003-9861(84)90028-6
Huang, J. M., Xi, P. G., Deng, Y. Z., Huang, W. X., Wang, J. R., Zhao, Q. Q., et al. (2021). The Mitogen-Activated Protein Kinase PlMAPK2 Is Involved in Zoosporogenesis and Pathogenicity of Peronophythora litchii. Int. J. Mol. Sci. 22:3524. doi: 10.3390/ijms22073524
Ikeyama, Y., Tasaka, M., and Fukaki, H. (2010). RLF, a cytochrome b5-like heme/steroid binding domain protein, controls lateral root formation independently of ARF7/19-mediated auxin signaling in Arabidopsis thaliana. Plant J. 62, 865–875. doi: 10.1111/j.1365-313X.2010.04199.x
Jiang, L., Situ, J., Deng, Y. Z., Wan, L., Xu, D., Chen, Y., et al. (2018). PlMAPK10, a Mitogen-Activated protein kinase (MAPK) in Peronophythora litchii, is required for mycelial growth, sporulation, laccase activity, and plant infection. Front. Microbiol. 9:426. doi: 10.3389/fmicb.2018.00426
Jiang, L., Ye, W., Situ, J., Chen, Y., Yang, X., Kong, G., et al. (2017). A Puf RNA-binding protein encoding gene PlM90 regulates the sexual and asexual life stages of the litchi downy blight pathogen Peronophythora litchii. Fungal Genet. Biol. 98, 39–45. doi: 10.1016/j.fgb.2016.12.002
Kandel, S. E., and Lampe, J. N. (2014). The role of protein-protein interactions in cytochrome P450-mediated drug metabolism and toxicity. Chem. Res. Toxicol. 27, 1474–1486. doi: 10.1021/tx500203s
Keyes, S. R., Alfano, J. A., Jansson, I., and Cinti, D. L. (1979). Rat liver microsomal elongation of fatty acids. Possible involvement of cytochrome b5. J. Biol. Chem. 254, 7778–7784. doi: 10.1016/S0021-9258(18)36015-0
Kimura, I., Nakayama, Y., Konishi, M., Terasawa, K., Ohta, M., Itoh, N., et al. (2012). Functions of MAPR (Membrane-Associated progesterone receptor) family members as heme/steroid-binding proteins. Curr. Protein Pept. Sci. 13, 687–696. doi: 10.2174/138920312804142110
Kimura, I., Nakayama, Y., Yamauchi, H., Konishi, M., Miyake, A., Mori, M., et al. (2008). Neurotrophic activity of neudesin, a novel extracellular heme-binding protein, is dependent on the binding of heme to its cytochrome b5-like heme/steroid-binding domain. J. Biol. Chem. 283, 4323–4331. doi: 10.1074/jbc.M706679200
Klingberg, S., Andersson, H., Mulligan, A., Bhaniani, A., Welch, A., Bingham, S., et al. (2008). Food sources of plant sterols in the EPIC Norfolk population. Eur. J. Clin. Nutr. 62, 695–703. doi: 10.1038/sj.ejcn.1602765
Kong, G., Chen, Y., Deng, Y., Feng, D., Jiang, L., Wan, L., et al. (2020). The basic leucine zipper transcription factor PlBZP32 associated with the oxidative stress response is critical for pathogenicity of the lychee downy blight oomycete Peronophythora litchii. Msphere 5, e00261–20. doi: 10.1128/mSphere.00261-20
Kong, G., Li, T., Huang, W., Li, M., Shen, W., Jiang, L., et al. (2021). Detection of Peronophythora litchii on lychee by loop-mediated isothermal amplification assay. Crop Prot. 139:105370. doi: 10.1016/j.cropro.2020.105370
Kong, G., Wan, L., Deng, Y., Yang, W., Li, W., Jiang, L., et al. (2019). Pectin acetylesterase PAE5 is associated with the virulence of plant pathogenic oomycete Peronophythora litchii. Physiol. Mol. Plant Pathol. 106, 16–22. doi: 10.1016/j.pmpp.2018.11.006
Kong, L. A., Yang, J., Li, G. T., Qi, L. L., Zhang, Y. J., Wang, C. F., et al. (2012). Different chitin synthase genes are required for various developmental and plant infection processes in the rice blast fungus Magnaporthe oryzae. PLoS Pathog. 8:e1002526. doi: 10.1371/journal.ppat.1002526
Lamb, C., and Dixon, R. A. (1997). The oxidative burst in plant disease resistance. Annu. Rev. Plant Physiol. Plant Mol. Biol. 48, 251–275. doi: 10.1146/annurev.arplant.48.1.251
Lamb, D. C., Kelly, D. E., Manning, N. J., Kaderbhai, M. A., and Kelly, S. L. (1999). Biodiversity of the P450 catalytic cycle: yeast cytochrome b5/NADH cytochrome b5 reductase complex efficiently drives the entire sterol 14-demethylation (CYP51) reaction. FEBS Lett. 462, 283–288. doi: 10.1016/s0014-5793(99)01548-3
Li, H., Ma, L., Hu, Z., Tu, Y., Jiang, C., Wu, Q., et al. (2019). Heterologous expression of AoD9D enhances salt tolerance with increased accumulation of unsaturated fatty acid in transgenic Saccharomyces cerevisiae. J. Ind. Microbiol. Biotechnol. 46, 231–239. doi: 10.1007/s10295-018-02123-9
Liu, H., Jing, G., Jiang, Y., Luo, F., and Li, Z. (2017). The effect of carbamic acid, (1,2,3-thiadiazole-4-ylcarbonyl)-hexyl ester on Peronophythora litchii infection, quality and physiology of postharvest litchi fruits. Chem. Cent. J. 11:14. doi: 10.1186/s13065-017-0244-x
Livak, K. J., and Schmittgen, T. D. (2001). Analysis of relative gene expression data using real-time quantitative PCR and the 2(-Delta Delta C(T)) Method. Methods 25, 402–8. doi: 10.1006/meth.2001.1262
Martin, S. W., and Konopka, J. B. (2004). Lipid Raft Polarization Contributes to Hyphal Growth in Candida albicans. Eukaryot. Cell. 3, 675–684. doi: 10.1128/EC.3.3.675-684.2004
Matteis, F. D., Ballou, D. P., Coon, M. J., Estabrook, R. W., and Haines, D. C. (2012). Peroxidase-like activity of uncoupled cytochrome P450: studies with bilirubin and toxicological implications of uncoupling. Biochem. Pharmacol. 84, 374–382. doi: 10.1016/j.bcp.2012.04.016
Mayer, A. M., and Staples, R. C. (2002). Laccase: new functions for an old enzyme. Phytochemistry 60, 551–565. doi: 10.1016/s0031-9422(02)00171-1
Medina, M. V., and Platt, H. W. (1999). Comparison of different culture media on the mycelial growth, sporangia and oospore production of Phytophthora infestans. Am. J. Potato Res. 76, 121–125. doi: 10.1007/BF02853576
Michaelson, L. V., Markham, J. E., Zäeuner, S., Matsumoto, M., Chen, M., Cahoon, E. B., et al. (2013). Identification of a cytochrome b5-fusion desaturase responsible for the synthesis of triunsaturated sphingolipid long chain bases in the marine diatom Thalassiosira pseudonana. Phytochemistry 90, 50–55. doi: 10.1016/j.phytochem.2013.02.010
Mifsud, W., and Bateman, A. (2002). Membrane-bound progesterone receptors contain a cytochrome b5-like ligand-binding domain. Genome Biol. 3:research0068.1. doi: 10.1186/gb-2002-3-12-research0068
Molina, L., and Kahmann, R. (2007). An Ustilago maydis Gene Involved in H2O2 Detoxification Is Required for Virulence. Plant Cell 19, 2293–2309. doi: 10.1105/tpc.107.052332
Napier, J. A., Sayanova, O., Sperling, P., and Heinz, E. (1999). A growing family of cytochrome b5-domain fusion proteins. Trends Plant Sci. 4, 2–4. doi: 10.1016/S1360-1385(98)01357-0
Nes, W. D., and Stafford, A. E. (1983). Evidence for metabolic and functional discrimination of sterols by Phytophthora cactorum. Proc. Natl. Acad. Sci. U. S. A. 80, 3227–3231. doi: 10.1073/pnas.80.11.3227
Porter, T. D. (2002). The roles of cytochrome b5 in cytochrome P450 reactions. J. Biochem. Mol. Toxicol. 16, 311–316. doi: 10.1002/jbt.10052
Rudolph, M. J., Johnson, J. L., Rajagopalan, K. V., and Kisker, C. (2003). The 1.2 Å structure of the human sulfite oxidase cytochrome b5 domain. Acta Crystallogr. D. 59, 1183–1191. doi: 10.1107/s0907444903009934
Sayanova, O., Smith, M. A., Lapinskas, P., Stobart, K., Dobson, G., Christie, W. W., et al. (1997). Expression of a borage desaturase cDNA containing an N-terminal cytochrome b5 domain results in the accumulation of high levels of Δ6-desaturated fatty acids in transgenic tobacco. Proc. Natl. Acad. Sci. U. S. A. 94, 4211–4216. doi: 10.1073/pnas.94.8.4211
Schenkman, J. B., and Jansson, I. (2003). The many roles of cytochrome b5. Pharmacol. Ther. 97, 139–152. doi: 10.1016/s0163-7258(02)00327-3
Sheng, Y., Wang, Y., Meijer, H. J. G., Yang, X., Hua, C., Ye, W., et al. (2015). The heat shock transcription factor PsHSF1 of Phytophthora sojae is required for oxidative stress tolerance and detoxifying the plant oxidative burst. Environ. Microbiol. 17, 1351–1364. doi: 10.1111/1462-2920.12609
Situ, J., Jiang, L., Fan, X., Yang, W., Li, W., Xi, P., et al. (2020a). An RXLR effector PlAvh142 from Peronophythora litchii triggers plant cell death and contributes to virulence. Mol. Plant Pathol. 21, 415–428. doi: 10.1111/mpp.12905
Situ, J., Jiang, L., Shao, Y., Kong, G., Xi, P., and Jiang, Z. (2020b). Establishment of CRISPR/Cas9 genome editing system in Peronophythora litchii. J. Fungal Res. 18, 181–188. doi: 10.13341/j.jfr.2020.1355
Srivastava, A., Singh, S. S., and Mishra, A. K. (2014). Modulation in fatty acid composition influences salinity stress tolerance in Frankia strains. Ann. Microbiol. 64, 1315–1323. doi: 10.1007/s13213-013-0775-x
Stong, R. A., Kolodny, E., Kelsey, R. G., González-Hernández, M. P., Vivanco, J. M., and Manter, D. K. (2013). Effect of Plant Sterols and Tannins on Phytophthora ramorum Growth and Sporulation. J. Chem. Ecol. 39, 733–743. doi: 10.1007/s10886-013-0295-y
Syed, K., Kattamuri, C., Thompson, T. B., and Yadav, J. S. (2011). Cytochrome b5 reductase–cytochrome b5 as an active P450 redox enzyme system in Phanerochaete chrysosporium: atypical properties and in vivo evidence of electron transfer capability to CYP63A2. Arch. Biochem. Biophys. 509, 26–32. doi: 10.1016/j.abb.2011.02.023
Takashi, S., Katsuyoshi, M., and Ryo, S. (1972). Reconstitution of hepatic microsomal stearoyl-coenzyme a desaturase system from solubilized components. J. Biochem. 5, 1163–1174. doi: 10.1093/oxfordjournals.jbchem
van West, P. V., Kamoun, S., van’t Klooster, J. W., and Govers, F. (1999). Internuclear gene silencing in Phytophthora infestans. Mol. Cell 3, 339–348. doi: 10.1016/s1097-2765(00)80461-x
Yang, Y., Fan, F., Zhuo, R., Ma, F., Gong, Y., Wan, X., et al. (2012). Expression of the laccase gene from a white rot fungus in Pichia pastoris can enhance the resistance of this yeast to H2O2-mediated oxidative stress by stimulating the glutathione-based antioxidative system. Appl. Environ. Microbiol. 78, 5845–5854. doi: 10.1128/AEM.00218-12
Ye, W., Wang, Y., Shen, D., Li, D., Pu, T., Jiang, Z., et al. (2016). Sequencing of the litchi downy blight pathogen reveals it is a Phytophthora species with downy mildew-like characteristics. Mol. Plant-Microbe Interact. 29, 573–583. doi: 10.1094/MPMI-03-16-0056-R
Zhang, M., and Scott, J. G. (1994). Cytochrome b5 involvement in cytochrome P450 monooxygenase activities in house fly microsomes. Arch. Insect. Biochem. Physiol. 27, 205–216. doi: 10.1002/arch.940270306
Zhong, H. Y., Chen, J. W., Li, C. Q., Chen, L., Wu, J. Y., Chen, J. Y., et al. (2011). Selection of reliable reference genes for expression studies by reverse transcription quantitative real-time PCR in litchi under different experimental conditions. Plant Cell Rep. 30, 641–653. doi: 10.1007/s00299-010-0992-8
Keywords: Peronophythora litchii, cytochrome b5-like heme/steroid binding domain, growth, pathogenicity, oxidative stress
Citation: Li W, Li P, Zhou X, Situ J, Lin Y, Qiu J, Yuan Y, Xi P, Jiang Z and Kong G (2021) A Cytochrome B5-Like Heme/Steroid Binding Domain Protein, PlCB5L1, Regulates Mycelial Growth, Pathogenicity and Oxidative Stress Tolerance in Peronophythora litchii. Front. Plant Sci. 12:783438. doi: 10.3389/fpls.2021.783438
Received: 26 September 2021; Accepted: 01 November 2021;
Published: 25 November 2021.
Edited by:
Meixiang Zhang, Nanjing Agricultural University, ChinaReviewed by:
Yu Du, Northwest A&F University, ChinaWenjun Zhu, Wuhan Polytechnic University, China
Guangyuan Xu, China Agricultural University, China
Copyright © 2021 Li, Li, Zhou, Situ, Lin, Qiu, Yuan, Xi, Jiang and Kong. This is an open-access article distributed under the terms of the Creative Commons Attribution License (CC BY). The use, distribution or reproduction in other forums is permitted, provided the original author(s) and the copyright owner(s) are credited and that the original publication in this journal is cited, in accordance with accepted academic practice. No use, distribution or reproduction is permitted which does not comply with these terms.
*Correspondence: Zide Jiang, emRqaWFuZ0BzY2F1LmVkdS5jbg==; Guanghui Kong, Z2tvbmdAc2NhdS5lZHUuY24=